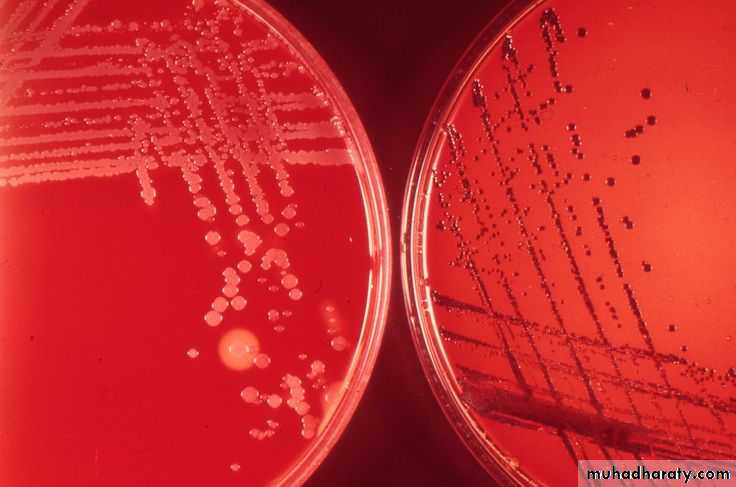
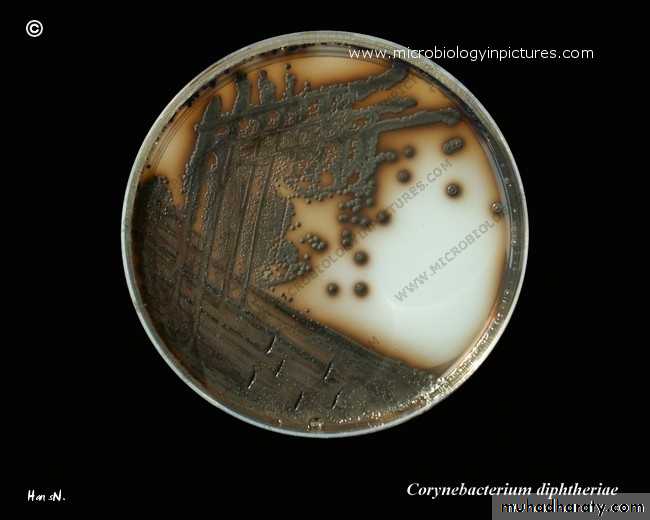
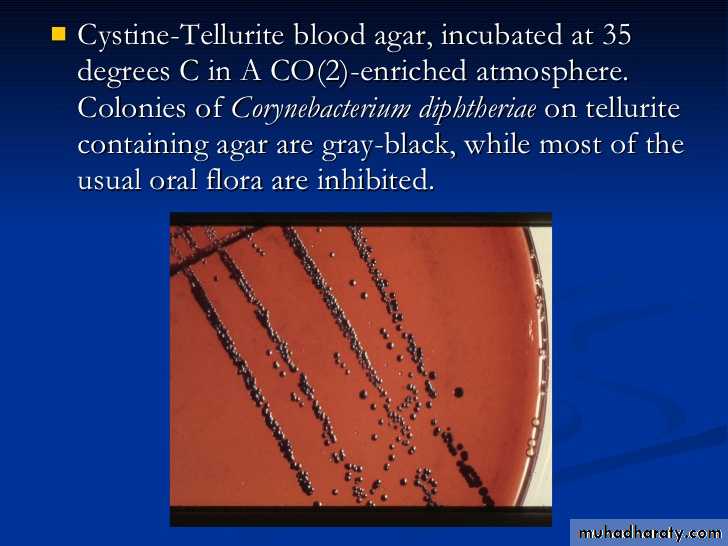
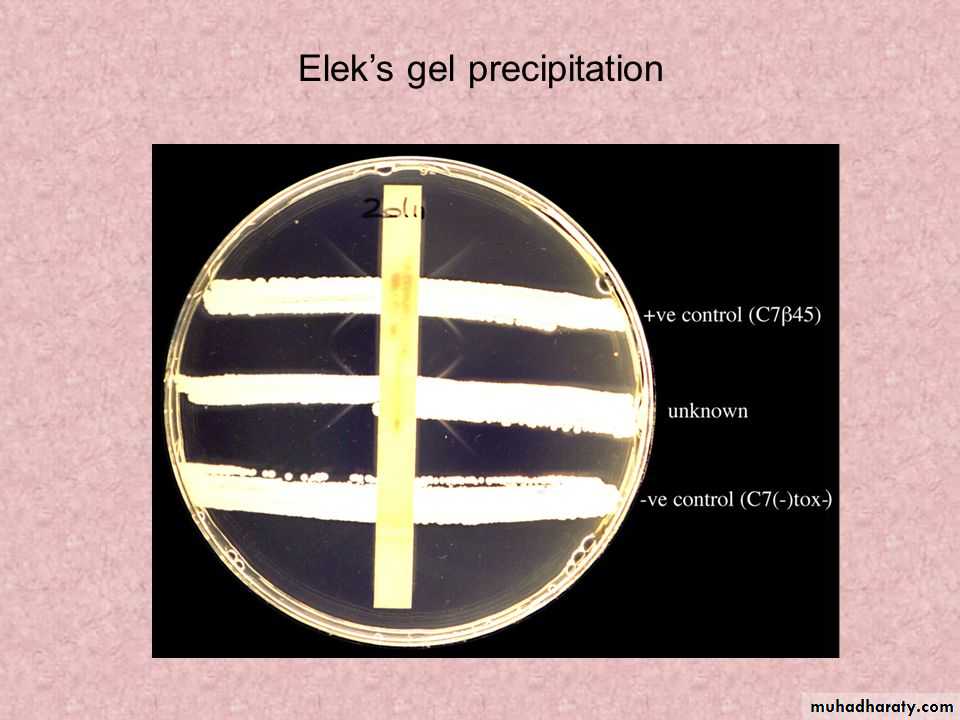

بسم الله الرحمن الرحيم
Corynebacterium diphtheriae
Corynebacteria are G+ bacteria, non motile, non spore forming.
They possess irregular swellings at one end that give them the “club-shaped” appearance.
Irregularly distributed within the rod (often near the poles) are granules staining deeply with aniline dyes (metachromatic* granules) that give the rod a beaded appearance.
• On blood agar, the C diphtheriae colonies are small, granular, and gray with irregular edges and may have small zones of hemolysis.
• On agar containing potassium tellurite, the colonies are brown to black with a brown-black halo because the tellurite is reduced intracellularly.
On potassium tellurite agar
• Four biotypes of C diphtheriae have been widely recognized and each of them produces the exotoxin: gravis, mitis, intermedius, and belfanti.
• These biotypes classified according to the colony morphology, biochemical reactions, molecular methods such as ribotyping and severity of disease produced by infection.
Corynebacteria tend to pleomorphism in microscopic and colonial morphology. When some nontoxigenic diphtheria organisms are infected with bacteriophage from certain toxigenic diphtheria bacilli, the offspring of the exposed bacteria are lysogenic and toxigenic, and this trait is subsequently hereditary.
When toxigenic diphtheria bacilli are serially subcultured in specific antiserum against the temperate phage that they carry, they tend to become nontoxigenic. Thus, acquisition of phage leads to toxigenicity (lysogenic conversion).
Pathogenesis
The principal human pathogen of the genus Corynebacterium is C diphtheriae, the causative agent of respiratory or cutaneous diphtheria.C diphtheriae occurs in the respiratory tract, in wounds, or on the skin of infected persons or normal carriers.
It is spread by droplets or by contact to susceptible individuals; the bacilli then grow on mucous membranes or in skin abrasions, and those that are toxigenic start producing toxin.
Diphtheria toxin
• single-chain, polypeptide. If disulfide bonds are broken, the molecule can be split into two fragments.• Fragment B, which has no independent activity, is functionally divided into a receptor domain and a translocation domain.
• The binding of the receptor domain to host cell membrane proteins CD-9 and heparin-binding epidermal growth factor (HB-EGF) triggers the entry of the toxin into the cell through receptor-mediated endocytosis.
• Acidification of the translocation domain within a developing endosome leads to formation of a protein channel that facilitates movement of Fragment A into the host cell cytoplasm.
Fragment A inhibits polypeptide chain elongation—provided nicotinamide adenine dinucleotide (NAD) is present—by inactivating the elongation factor EF-2.
This factor is required for translocation of polypeptidyl-transfer RNA from the acceptor to the donor site on the eukaryotic ribosome. Toxin Fragment A inactivates EF-2 that abrupt arrest of protein synthesis is responsible for the necrotizing and neurotoxic effects of diphtheria toxin.
Pathology
*Diphtheria toxin is absorbed into the mucous membranes and causes destruction of epithelium and a superficial inflammatory response.*The necrotic epithelium becomes embedded in exuding fibrin and red and white cells, so that a grayish “pseudomembrane” is— commonly over the tonsils, pharynx, or larynx.
*Enlarge of lymph nodes in the neck, and edema of the entire neck, with distortion of the airway.
• The diphtheria within the membrane continue to produce toxin actively, toxic damage,
• fatty infiltration, and necrosis in heart muscle (myocarditis), liver, kidneys (tubular necrosis), and adrenal glands, sometimes accompanied by hemorrhage.• The toxin also produces nerve damage (demyelination), often resulting in paralysis of eye muscles.
Diphtheria can cause a swollen neck, sometimes referred to as a bull neck.
Wound or skin diphtheria occurs mostly in the tropics, in alcoholic, homeless individuals, and other poor groups.
A membrane may form on an infected wound that fails to heal. However, absorption of toxin is usually slight and the systemic effects small.
The small amount of toxin that is absorbed during skin infection promotes development of antitoxin antibodies.
Clinical Findings
• When diphtheritic inflammation begins in the respiratory tract, sore throat and low-grade fever usually develop.• Prostration and dyspnea soon follow because of the obstruction caused by the membrane.
• This obstruction may even cause suffocation if not promptly relieved by intubation or tracheostomy.
• Irregularities of cardiac rhythm indicate damage to the heart. Later, there may be difficulties with vision, speech, swallowing of the arms or legs.
Diagnostic Laboratory Tests
*swabs from the nose, throat, or other suspected lesions must be obtained before antimicrobial drugs are administered.*Smears stained with alkaline methylene blue or Gram stain show beaded rods in typical arrangement.
Cultures:
Specimens should be inoculated to a blood agar plate and a selective medium such as a tellurite plate (eg, cystine-tellurite blood agar [CTBA] and incubated at 37°C in 5% CO2.
Plates should be examined in 18–24 hours. In 36–48 hours, the colonies on tellurite medium are sufficiently definite for recognition of C diphtheriae. On cystine tellurite agar, the colonies are black with a brown halo.
1. Modified Elek immunoprecipitation method. A filter paper disk containing antitoxin (10 IU/disk) is placed on an agar plate. The cultures to be tested (at least 10 colonies should be chosen) for toxigenicity are spot inoculated 7–9 mm away from the disk. After 48 hours of incubation, the antitoxin diffusing from the paper
disk has precipitated the toxin diffusing from toxigenic cultures and has resulted in precipitin bands between the disk and the bacterial growth.
2. PCR described for detection of the diphtheria toxin gene (tox). PCR assays for tox can also be used directly on patient specimens before culture results are available.
3. Enzyme-linked immunosorbent assays can be used to detect diphtheria toxin from clinical C diphtheria isolates.
4. An immunochromatographic strip assay allows detection of diphtheria toxin in a matter of hours.
Treatment
• The treatment of diphtheria depending on rapid suppression of toxin-producing bacteria by antimicrobial drugs and the early administration of specific antitoxin against the toxin formed by the organisms at their site of entry and multiplication.• Diphtheria antitoxin is produced in various animals (horses, sheep, goats, and rabbits) by the repeated injection of purified and concentrated toxoid.
• From 20,000 to 120,000 units are injected intramuscularly or intravenously depending on the duration of symptoms and severity of illness after suitable precautions have been taken (skin test) to rule out hypersensitivity to the animal serum.
Antimicrobial drugs (penicillin, macrolides) inhibit the growth of diphtheria bacilli. Although these drugs have virtually no effect on the disease process, they arrest toxin production and assist public health efforts. They also help to eliminate coexistent streptococci and C diphtheriae from the respiratory tracts of patients or carriers. Antimicrobial resistance to these agents is rare.